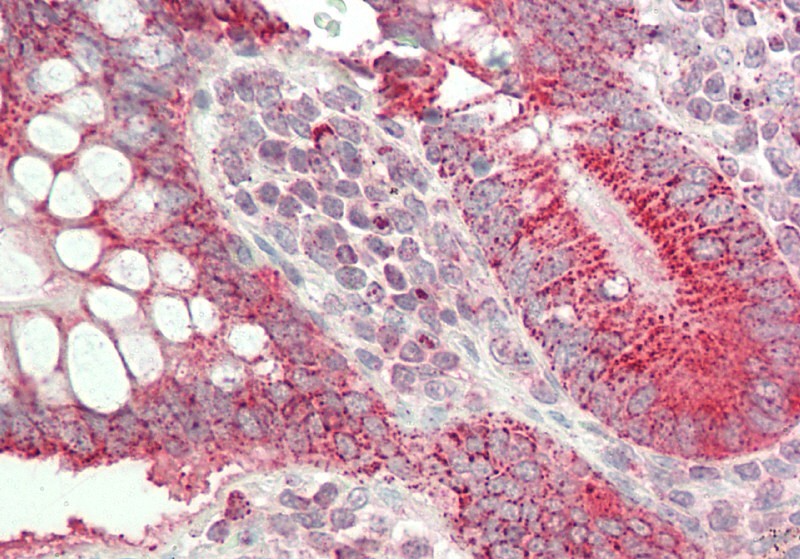

Polyclonal Antibody to Chaperonin
Fig-1: Western blot analysis of Chaperonin . Anti- Chaperonin antibody (11-8015) was used at 1 µg/ml on 1) EL4, 2) A549, 3) A431 and 4) 293 lysates.
Roll over image to zoom in
Shipping Info:
Order now and get it on Tuesday March 31, 2026
Same day delivery FREE on San Diego area orders placed by 1.00 PM
| Format : | Purified |
| Amount : | 100 µg |
| Isotype : | Rabbit IgG |
| Purification : | Protein A Chromatography |
| Content : | 25 µg in 50 µl/100 µg in 200 µl PBS containing 0.05% BSA and 0.05% sodium azide. Sodium azide is highly toxic. |
| Storage condition : | Store the antibody at 4°C, stable for 6 months. For long-term storage, store at -20°C. Avoid repeated freeze and thaw cycles. |
HSPD1 (heat shock 60 kDa protein 1 (chaperonin)) is a member of the chaperonin family of proteins. Chaperonin may function as a signaling molecule in the innate immune system and is essential for the folding and assembly of newly imported proteins in the mitochondria implicated in mitochondrial protein import and macromolecular assembly. Diseases associated with HSPD1 include spastic paraplegia 13. It exists in two isoforms comprised of 573 amino acids. Chaperonin is expressed in adipose tissue, adrenal cortex, adrenal gland, blood and brain.
Western blot analysis: 1-3 µg/ml, Immunohistochemical analysis: 5 µg/ml
For Research Use Only. Not for use in diagnostic/therapeutics procedures.
| Subcellular location: | Mitochondrion matrix |
| BioGrid: | 109561. 301 interactions. |
|
There are currently no product reviews
|

.png)













